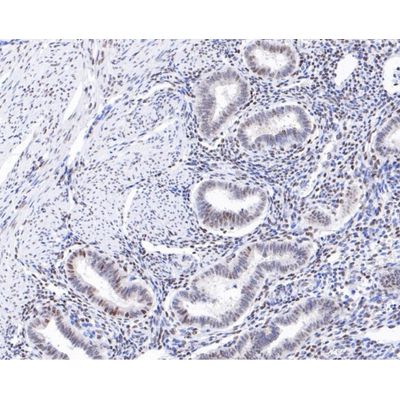

Huabio
Huabio - Model ST05-25 -ET1609-67 -HIF-1 Beta Recombinant Rabbit Monoclonal Antibody
FromHuabio
Western blot analysis of HIF-1 beta on human liver tissue lysates. Proteins were transferred to a PVDF membrane and blocked with 5% BSA in PBS for 1 hour at room temperature. The primary antibody (ET1609-67, 1/500) was used in 5% BSA at room temperature for 2 hours. Goat Anti-Rabbit IgG - HRP Secondary Antibody (HA1001) at 1:5,000 dilution was used for 1 hour at room temperature.
Most popular related searches
monoclonal antibody
liver tissue
western blot analysis
western blot
secondary antibody
primary antibody
recombinant antibody
cancer research
- Product Type Recombinant Rabbit monoclonal primary
- Product Name HIF-1 beta Recombinant Rabbit Monoclonal Antibody [ST05-25] (ET1609-67)
- Immunogen Recombinant protein within human hif-1 beta aa 479-789 / 789.
- Host Rabbit
- Positive Control Human liver tissue lysates, human liver tissue, human fallopian tube tissue, human placenta tissue, human uterus tissue.
- Conjugation Unconjugated
- Clonality Monoclonal
- Clone Number ST05-25
- WB 1:1,000-1:2,000
- IHC-P 1:50-1:200
- Form Liquid
- Storage Condition Store at +4C after thawing. Aliquot store at -20C or -80C. Avoid repeated freeze / thaw cycles.
- Storage Buffer 1*TBS (pH7.4), 0.05% BSA, 40% Glycerol. Preservative: 0.05% Sodium Azide.
- Concentration 1ug/ul
- Purification Protein A affinity purified.
- Molecular Weight 87 kDa
- Isotype IgG
